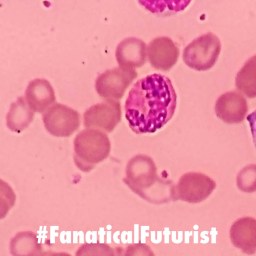

WHY THIS MATTERS IN BRIEF
Genetic engineering is the ultimate Pandora’s Box, and the lid’s coming off as companies discover new ways to control and kill pests in the wild.
Interested in the Exponential Future? Connect, download a free E-Book, watch a keynote, or browse my blog.
Let’s play a game… what’s the most dangerous and lethal weapon on the planet according to the United Nations? Nope, it’s a Gene Drive. In short a gene drive is a type of genetic tool that ensures the changes you make to an organisms DNA using a gene editing tool like CRISPR persists and is passed down through the generations – forever. Now, if that genetic change is a positive one, such as preventing an inherited genetic disease being passed down through the generations then that’s obviously a good thing, and this is one reason why we’re now seeing the arrival of designer babies, but if that change is malicious, well, that’s how you wipe out entire species including, with some mammalian tweaking, the human race… And that’s why gene drives, not nuclear weapons, you guessed nuclear weapons right, are the most lethal weapon on the planet.
So far gene drives have been used to wipe out invasive species like rats and mice on islands, as well as Mosquitos in Brazil by making sure they only give birth to male offspring, and now, getting closer to home scientists have released genetically modified male diamondback moths in New York State that are designed to wipe out pest populations, and the field trial, which took place recently, shows that these GM moths, whose female offspring die soon after hatching, could help control this major crop pest.
Oxitec, the British biotechnology company behind the trial, has already carried out field trials of this method for controlling mosquitoes that spread diseases such as dengue. However, the moth field trial is the first for a crop pest, the company says.
The larvae of the diamondback moth eat the leaves of brassica plants such as cabbage, kale, broccoli and oilseed rape. The moths are a major pest worldwide, causing damage estimated at $5 billion a year.
To create its GM moths, Oxitec added two genes to moths that are still susceptible to pesticides. One gene simply codes for a red fluorescent protein, so the insects can easily be identified in the wild.
The other gene kills larvae soon after they hatch – but it switches on only in females. When male GM moths mate with wild females, all the female offspring die, but the males survive and pass the lethal gene on to their offspring. Because half the offspring of the GM males die each generation, the lethal gene should disappear after just a few generations, and to continue to suppress wild populations, more GM males would need to be released.
In field trials in August and September 2017 at the Cornell University Agricultural Experiment Station in New York, between 1,000 and 2,500 males were released on six separate occasions. The researchers then recaptured some of the moths to confirm that they survived in the wild. They say the moths should be as competitive with wild male moths in mating with females as they were in lab trials done in the US and UK. As expected, the GM strain didn’t persist in the wild.
“We did not detect any of them hanging around,” says Neil Morrison of Oxitec.
The company hopes to get approval to start selling its GM diamondback moths to farmers in the US soon and it also plans to use the same technology to tackle other crop pests, such as the fall armyworm.
“The diamondback moth is a huge problem globally and evolves resistance to pesticides very rapidly,” says Michael Bonsall at the University of Oxford. “It’s super-invasive. We need new tools in the toolbox.”
But the GM moth will need to be used with other methods as part of an integrated approach, Bonsall says. “It’s not a silver bullet. It’s just another tool.”
However, whether we want a tool that literally and for good reason got coined as the “Extinction Gene” in the wild that could open up a Pandora’s Box of trouble, well, that’s up for discussion.
Journal reference: Frontiers in Bioengineering and Biotechnology, DOI: 10.3389/fbioe.2019.00482